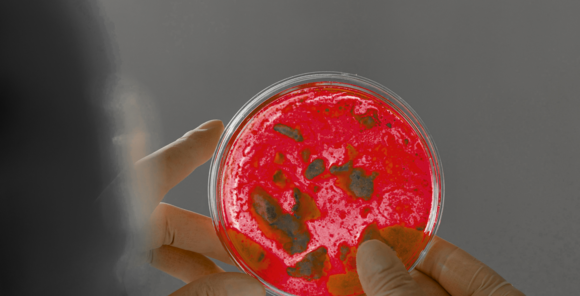
In the AI era, the survival of Chemicals & Life Sciences businesses depends on a cloud foundation

Companies often struggle to engage effectively with their diverse customer base. The Persona Engine by BearingPoint transforms this challenge into an opportunity, using AI to create dynamic, data-driven personas that represent real customers.
The Persona Engine revolutionizes customer segmentation by turning data into interactive personas, enabling personalized engagement, better product design, and targeted marketing. With just a few clicks, companies can visualize customer behavior, adapt strategies in real-time, and engage with different customer groups through chat, simulating direct interaction. The result? Higher conversion rates, improved customer retention, and increased satisfaction, all while enhancing operational efficiency and cutting costs.